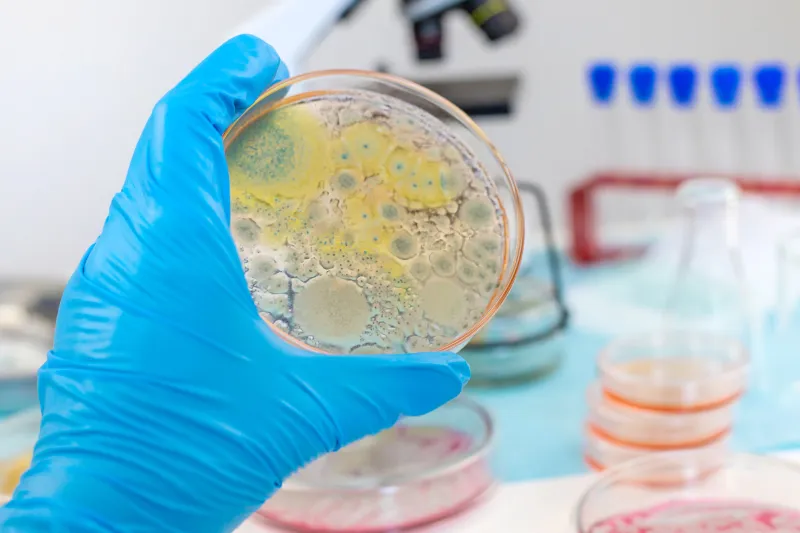
Antimicrobial prescribing

QUM Learning
Quality use of medicine (QUM) Learning provides a range of education and training courses on medication safety and quality use of medicines. QUM Learning resources are designed to improve the use of medicines and promote patient safety and quality of care.
Who it’s for?
Health professionals and students.
On completion
Certificates are available to learners upon course completion. These may be used as evidence of self-directed Continuing Professional Development (CPD) activity, or alignment with compliance standards as required by employers.
Registration and enrolment
You can create an account free of charge on QUM Learning. Once your registration is complete and you’ve logged in, you’ll be able to browse available courses and enrol yourself in any courses that are relevant to you.
To reduce duplication, please do not register multiple times.
Recently updated courses

UTIs in residential aged care homes
Explores the diagnostic approach to managing urinary tract infections in residents of aged care homes to reduce antibiotic resistance.

Case study - Otitis media
This activity examines and clarifies the role of antibiotics for acute otitis media, using two different patient presentations.

Case study - UTI
This activity examines and clarifies the role of antibiotics for urinary tract infections, using a patient presentation.
Featured courses

Medication Safety
Explore the various causes of medication errors and prevent errors from occurring in your workplace.

NSMC
Principles of safe prescribing and how to correctly use the National Standard Medication Charts (NSMC).
Antimicrobial prescribing
A collection of courses that deal with safe and appropriate antimicrobial prescribing in a hospital setting.

Clinical case studies
Clinical scenarios with questions to help you reflect on your medical decision-making skills and improve patient care.

BPMH
Get it right! Learn techniques that can improve your skills in taking the Best Possible Medication History (BPMH).

RTPM
SafeScript (Victoria and NSW) and ScriptCheck (WA) training modules for real-time prescription monitoring (RTPM).